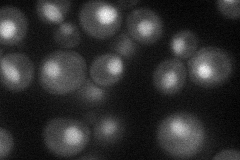
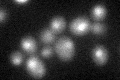

View description
Member of NineTeen Complex (NTC) that contains Prp19p and stabilizes U6 snRNA in catalytic forms of spliceosome containing U2, U5, and U6 snRNAs, interacts with Prp16p to modulate splicing fidelity; isy1 syf2 cells have defective spindles
Localization:
Intensity:
Fold change:
Significance:
-
C’ GFP library in SD

nucleus23.15 -
N' NOP1pr-GFP in SD
nucleus39.5746 -
N' TEF2pr-mCherry in SD

nucleus0 -
N' NATIVEpr-GFP in SD

nucleus28.1957 -
N' TEF2pr-VC and Cyto-VN in SD

#N/A0 -
C’ GFP library in SD+DTT
nucleus25.471.1No -
C’ GFP library in SD+H2O2

nucleus19.950.86No -
C’ GFP library in Starvation Media

nucleus24.811.07No -
C’ GFP library on the background of Pup2-DaMP

nucleus -
C’ GFP library on the background of CCT mutant

nucleus20.27070.875261No
